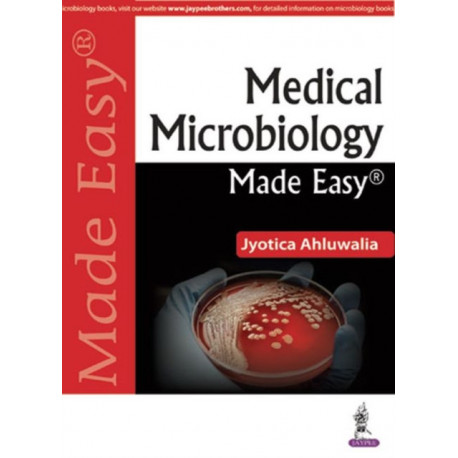

Kurv
Vare
varer
(tom)
Ingen varer
Fastlægges senere
Forsendelse
0,- kr
I alt
Medical Microbiology Made Easy
(Bog, Paperback / softback, Engelsk)
Beskrivelse
Comprehensive guide to microbiology for undergraduate and postgraduate students. Covers subspecialties including immunology, parasitology and virology. Presented in a text and bullet point format to emphasise key learning points and includes self-assessment questions to assist revision.
Læsernes anmeldelser (0)
Alle detaljer
| Forlag | Jaypee Brothers Medical Publishers |
| Forfatter | Jyotica Ahluwalia |
| Type | Bog |
| Format | Paperback / softback |
| Sprog | Engelsk |
| Udgivelsesdato | 30-11-2017 |
| Første udgivelsesår | 2017 |
| Illustrationer | 62 Halftones, color |
| Originalsprog | India |
| Sideantal | 430 |
| Indbinding | Paperback / softback |
| Forlag | Jaypee Brothers Medical Publishers |
| Sideoplysninger | 430 pages, 62 Halftones, color |
| Mål | 124 x 185 x 20 |
| ISBN-13 / EAN-13 | 9789352700974 |


